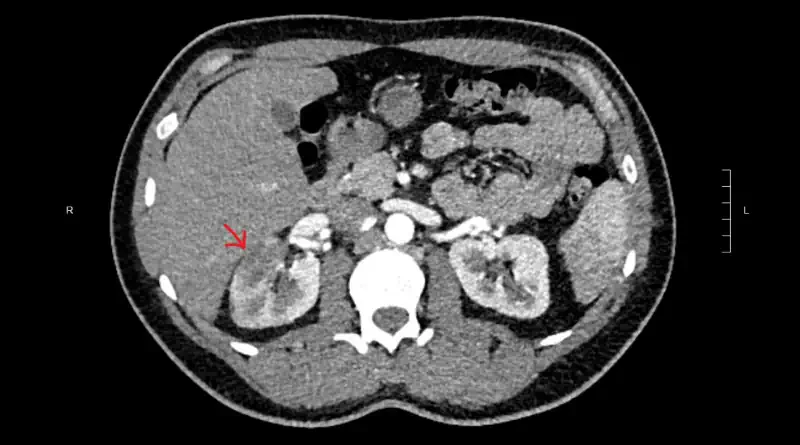

Artery Blood Clot
Usually, when we say “blood clot”, we actually mean “blood clot in a vein”. But sometimes blood clots happen in arteries. An artery blood clot is different than a clot in a vein.
What does “Artery Blood Clot” Mean?
Artery blood clot can mean one of three things:
- Blockages in arteries throughout the body. These blockages are usually the result of atherosclerosis.
- Clots that traveled from another artery or from the heart. These clots eventually block an artery somewhere.
- Blood clots in arteries might happen if there is a strong tendency for clotting. There are only a handful of conditions that can cause such a strong tendency.
Where do Artery Blood Clots Happen?
Theoretically, an artery blood clot can happen in any artery of the body. But some locations are more common. Here are a few examples:
- Stroke
- Myocardial infarction (“heart attack”)
- Mesenteric ischemia (blocked artery to the intestines)
- Leg ischemia (blocked artery to the legs). When this happens suddenly, it causes acute limb ischemia. A common symptom will be sudden onset rest pain.
Diagnosis
To diagnose a clot in an artery, we need to combine two factors:
- Symptoms
- Vascular testing
The symptoms will depend on the artery that is blocked. So, if an artery in the brain is blocked, this will cause a stroke. But if an artery in the heart is blocked, the symptoms will be those of myocardial ischemia (lack of blood flow to the heart muscle).
Vascular imaging should prove that an artery is blocked. We choose the type of study depending on the location. If we suspect a blocked brain or heart artery, we might choose a CT or MRI. But if we suspect a blocked artery in the arm or leg, we can also use ultrasound.
Special Testing for Artery Blood Clots
Whenever an artery blood clot happens, we need to understand the cause. This is important, because treatment is not the same for different causes. For instance, if we suspect atherosclerosis, we will probably want to add medicines to reduce lipid levels and to manage blood pressure. On the other hand, if we suspect the clot generated in the heart, we will probably look for an arrhythmia.
Testing for a Tendency to Clot
There is only a handful of conditions that can cause clots to form directly in arteries. If we suspect a clot did not travel from the heart, we should look for these conditions:
- Cancer
- Buerger’s disease (also known as thromboangiitis obliterans)
- Antiphospholipid antibody syndrome
- Paroxysmal Nocturnal Hemoglobinuria (PNH)
- Heparin induced thrombocytopenia and thrombosis (HITT)
Artery Blood Clot Treatment
The treatment of clots in the arteries has two parts:
- Treating the artery blockage
- Eliminating the cause
In many cases, we can open blocked arteries with procedures. For instance, if a patient has a large myocardial infarction, for instance, quickly opening the blocked artery will help keep the heart functioning. Still, we must remember that in many cases we should avoid procedures. For instance, a blocked kidney artery can cause a renal infarction. We usually do not recommend opening the blocked kidney artery.
Equally important is to eliminate the cause of the blockage. What to do exactly depends on the specific cause. For instance, if the cause was cancer, then obviously treating the cancer is the solution. Or if the cause was heparin induced thrombocytopenia with thrombosis, then we should avoid heparin in the future.
